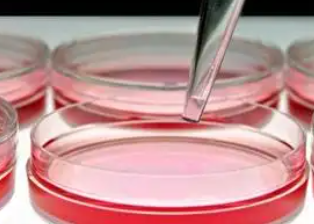
image.png

干細胞心肌肽的作用有什么,對心臟疾病有何幫助
2024-12-09 14:31:21 來源: 小編 咨詢醫(yī)生
干細胞心肌肽(Stem Cell Cardiomyocytes Peptide,簡稱SCCP)作為一種新興的生物活性物質(zhì),近年來在心臟疾病治療領(lǐng)域備受關(guān)注。本文將探討干細胞心肌肽的作用及其對心臟疾病的幫助。
一、干細胞心肌肽的作用
1.促進心肌細胞再生
干細胞心肌肽能夠促進心肌干細胞分化為心肌細胞,從而促進心肌細胞再生。這對于心臟疾病患者來說,可以有效修復受損的心肌組織,提高心臟功能。
2.改善心臟功能
干細胞心肌肽具有改善心臟功能的作用。它能增強心肌收縮力,降低心肌耗氧量,提高心臟輸出量,從而緩解心衰癥狀。
3.抗氧化應激
干細胞心肌肽具有較強的抗氧化作用,可以清除體內(nèi)多余的自由基,減輕氧化應激對心臟的損傷。
4.抗炎作用
干細胞心肌肽具有抗炎作用,能夠抑制炎癥因子釋放,減輕心臟炎癥反應,有利于心臟疾病的治療。
二、干細胞心肌肽對心臟疾病的幫助
1.心肌梗死
心肌梗死是心臟疾病中較為嚴重的一種,干細胞心肌肽可以促進梗死區(qū)心肌細胞的再生,改善心臟功能,降低梗死后心肌梗死的范圍,有利于患者康復。
2.心力衰竭
心力衰竭是心臟疾病晚期的一種表現(xiàn),干細胞心肌肽能夠改善心衰癥狀,提高心臟輸出量,延長患者生存時間。
3.心肌炎
心肌炎是由病毒、細菌等感染引起的心肌損傷,干細胞心肌肽具有抗炎作用,可以減輕心肌炎癥反應,促進心肌細胞修復。
4.心律失常
干細胞心肌肽可以改善心臟電生理特性,降低心律失常的發(fā)生風險。
三、結(jié)語
干細胞心肌肽作為一種新興的生物活性物質(zhì),在心臟疾病治療領(lǐng)域具有廣闊的應用前景。通過促進心肌細胞再生、改善心臟功能、抗氧化應激和抗炎作用,干細胞心肌肽為心臟疾病的治療提供了新的策略。然而,目前關(guān)于干細胞心肌肽的研究仍處于早期階段,未來還需要更多的臨床試驗和基礎(chǔ)研究,以驗證其在心臟疾病治療中的安全性和有效性。
- 2024-11-06南華大學在干細胞研究方面有哪些成果?其研究技術(shù)如何領(lǐng)先?
- 2024-10-18干細胞外泌體美容效果怎么樣,干細胞外泌體美容機制原理詳解
- 2024-10-08如何捐造血干細胞?有哪些條件和要求?
- 2024-10-28山東濟南造血干細胞捐獻流程是怎樣的?有什么注意事項?
- 2024-11-11人造血干細胞來源有哪些途徑,獲取方法有哪些
- 2024-10-22干細胞移植中藥效果有哪些?如何選擇?
- 2024-09-10免疫NK干細胞療法怎么樣,多少錢一個療程
- 2024-09-12怎樣選擇干細胞儲存機構(gòu),這五點至關(guān)重要
- 2024-09-17干細胞治療關(guān)節(jié)炎是真的嗎,關(guān)節(jié)炎干細胞治療原理效果
- 2024-09-24干細胞種植頭發(fā)全過程,干細胞植發(fā)技術(shù)成熟嗎
- 2024-10-07廣東人體干細胞有何神奇功效?與普通治療有何區(qū)別?
- 2024-09-04海南干細胞機構(gòu)有多少家,海南干細胞公司排名前十
- 2024-09-10干細胞特殊蛋白的功效和作用是什么
- 2024-08-12干細胞治療視網(wǎng)膜色素變性的原理
- 2024-08-21干細胞治療小兒自閉癥效果如何,是否值得嘗試
- 2024-08-04干細胞與抗衰老,干細胞抗衰老是不是騙局
- 2024-09-04干細胞抗衰老有效果嗎,有副作用嗎
- 2024-09-16干細胞恢復卵巢費用多少錢,恢復原理方法詳解
